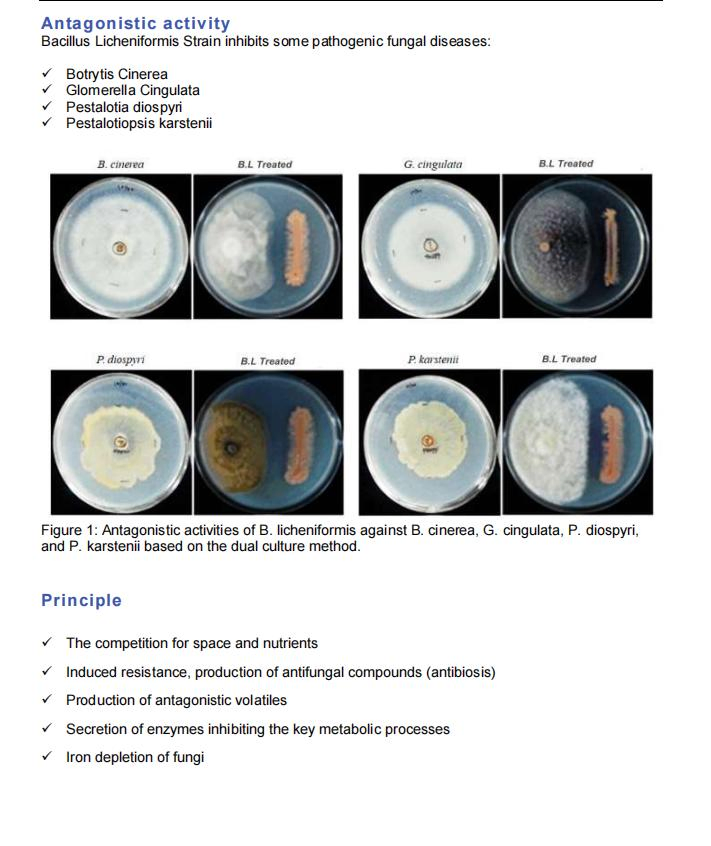
Boost Agriculture: B. Licheniformis Root Stimulator, Probiotic, and Fungicide

Introduction: Bacillus licheniformis is a soil-dwelling bacterium known for its ability to organic plant root stimulator and improve soil health in agriculture. It promotes crop growth through the production of plant growth-promoting compounds, such as indole acetic acid, gibberellins, and cytokinins. It increases fertility and promotes the growth of beneficial microorganisms.
Composition: Bacteria count: 1 x 10^11 cfu/g, 2 x 10^11 cfu/g. Formulation: Wettable Powder.
Antagonistic Activity: Biocontrols pathogenic fungal diseases including: Botrytis Cinerea, Glomerella Cingulata, Pestalotia diospyri, and Pestalotiopsis karstenii.
Biocontrol: Produces antimicrobial compounds (antibiotics, enzymes) to inhibit plant pathogens and outcompete them for nutrients.
Plant Growth-Promotion: Provides nutrients like nitrogen/phosphorus and produces rooting hormones (IAA/gibberellins).
Soil Health: Promotes decomposition of organic matter to improve soil structure and fertility.
Siderophores production: Chelates essential nutrients, making them more available to crops.
Works as plant root stimulator to boost stronger and healthy roots.
Natural fungicide for indoor plants; increases uptake of water and nutrients.
Increases plants' resistance to environmental stressors like salinity and drought.
Improves potential crop yield and increases VC & sugar content of fruit.
Soil treatment: Apply 1-3 kg per acre, mixed with water as a drench or in-furrow during planting. Reapply after 4-8 weeks.
Irrigation: Apply 2-3 gram per liter of water via drip irrigation. Reapply after 28 days for whole season control.
• 24 months shelf life when stored in a cool, dry place.
• Keep out of direct sunshine and moisture.
• Once opened, use within 30 days.
Can I get a free sample?
Yes, a 20-50 gram free sample can be provided, freight collect.
What is your Minimum Order Quantity (MOQ)?
For sample testing, the MOQ is 1 kg. For commercial orders, the total MOQ is 100 kgs.
Do you provide registration support?
Yes, we can support distributors with the necessary documentation for local registration.
Do you offer neutral packing or re-labeling?
Yes, neutral packing and re-labeling services can be offered upon request.
What are the payment terms and delivery time?
We accept T/T, L/C at sight, PayPal, and more. Delivery usually takes 10-20 days depending on quantity.